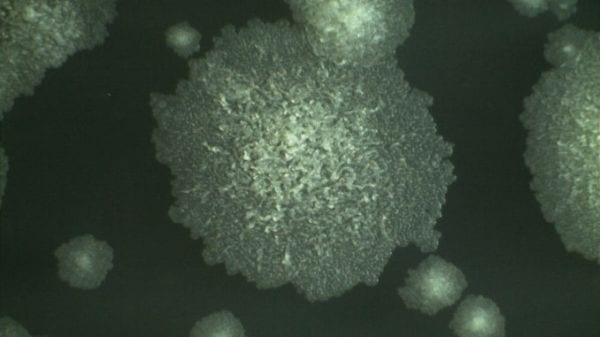

Un’ulcera carnivora che divora la pelle sta spaventando l’Australia e il resto del mondo: colpa del batterio mangia-carne, cos’è e come tenere sotto controllo l’allarme epidemia.
L’ulcera di Buruli solitamente colpisce gli abitanti dell’Africa occidentale e centrale ma di recente ha cominciato a preoccupare anche il popolo australiano. In effetti si tratta di un focolaio che rischia di scatenare una vera e propria epidemia e gli effetti non sono per nulla piacevoli visto che il batterio mangia-carne divora la pelle e provoca delle ulcere tanto dolorose quanto pericolose. Uno studio pubblicato sul Medical Journal of Australia Non ha certamente quietato gli animi: secondo gli esperti si tratta di un caso che richiede una “urgente risposta scientifica”.
I casi in effetti hanno cominciato a moltiplicarsi in maniera veloce, diventando al tempo stesso più gravi e manifestandosi in nuove aree geografiche. Purtroppo parlare delle cause è difficile: l’origine ambientale della malattia e il modo in cui si diffonde tra gli umani rimangono ancora sconosciuti. Se in Africa i principali vettori sono paludi e ambienti acquatici, in Australia a preoccupare sono zanzare e opossum. Il nome del batterio mangia-carne è Mycobacterium ulcerans e tra gli effetti vanno annoverate gravi lesioni distruttive della pelle e dei tessuti molli. Non meno preoccupante l’appartenenza del batterio alla stessa famiglia di organismi che causano la lebbra e la tubercolosi.
La progressione dell’infezione è devastante: a contatto con la pelle, il batterio si moltiplica producendo una tossina. Ad essere colpito è prima di tutto il tessuto adiposo: si parte col notare un piccolo nodulo, il quale nel giro di poco tempo si apre e crea l’ulcera. Come riconoscere l’arrivo dell’infezione e il suo progredire? Tra i sintomi cui fare attenzione ci sono una puntura sulla pelle con un bozzo che diventa più grande nel giro di giorni o settimane; il nodulo può creare una crosticina che diventa un’ulcera; questa si ingrandisce e, pur essendo indolore e priva di stadi febbrili, può causare addirittura amputazione di un arto, handicap o il decesso del paziente. C’è però una buona notizia: la maggior parte delle ulcere di Buruli può essere trattata con un ciclo di antibiotici orali, senza contare che una diagnosi precoce e un trattamento tempestivo possono ridurre al minimo la perdita della pelle.
LEGGI ANCHE: GASTRITE E ULCERA, LAMPONE E MORA PER GUARIRE
Photo credits Facebook
